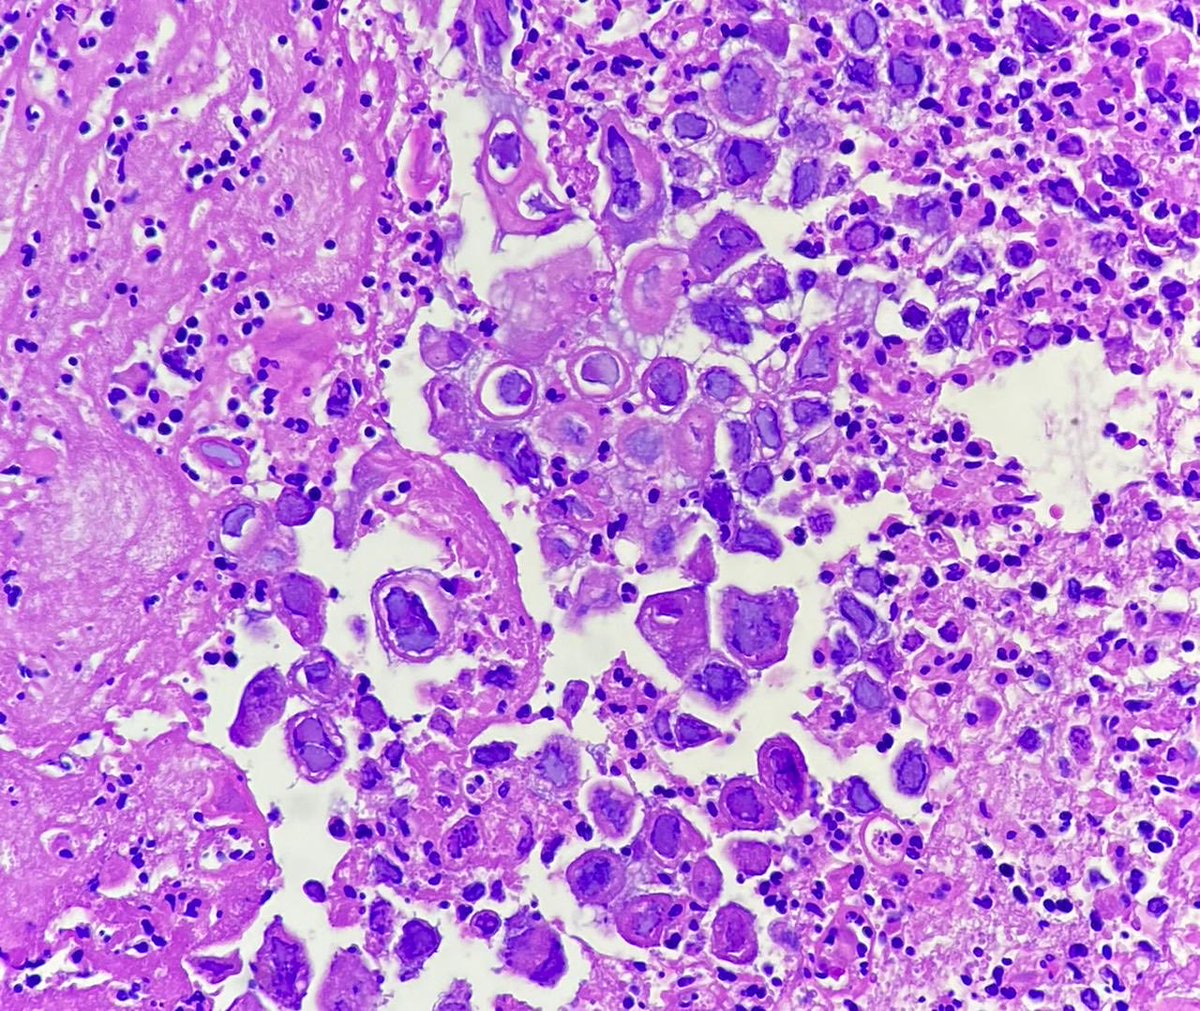
gauriii_23's tweet image. Oesophagus ulcer 38/M
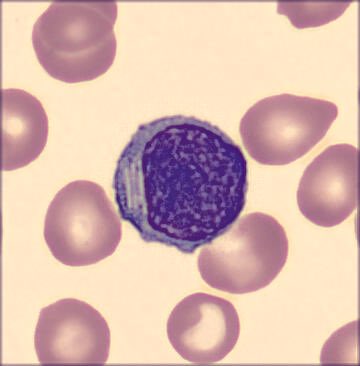
redb56's tweet image. #hemepath #pathology #hematology So, a patient with CLL came in today, and these showed up!
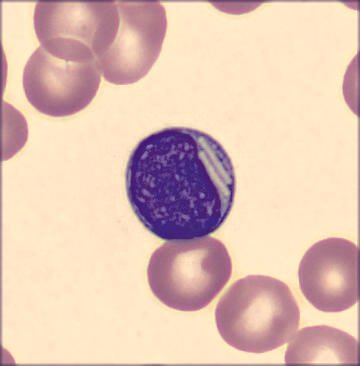
redb56's tweet image. #hemepath #pathology #hematology So, a patient with CLL came in today, and these showed up!

Mario Caviedes Cleves
@ClevesMario
Médico gral Usco👨🏻⚕ R3 Patología, UdeA 🔬 Especialista en formación, en Docencia Universitaria, UPC 📚 📍Medellín
You might like
Oesophagus ulcer 38/M

Diagnosis? #medicine #anatomy #medschool #pathology #histology #medlife #histologia #path #pathologists #fungi #fungus

Nice classic Henderson-Peterson bodies in molluscum contagiosum #PathTwitter #dermpath #dermatology

Conjunctival intraepithelial neoplasia. Thickened epithelium (acanthosis); increased cellularity. Loss of normal maturation sequence; disorganization. Dysplasia begins in basal layers and extends toward surface. Noninvasive. Chronic inflammatory infiltrate may be present. 👁️

#hemepath #pathology #hematology So, a patient with CLL came in today, and these showed up!

Tiny tiny lymph node that looked a little bit monotonous… what would you call it? #hemepath #PathTwitter @kirillkarlin



Skin nodule. Your diagnosis? Answer: kikoxp.com/posts/10372. Video: kikoxp.com/posts/4179 #pathology #pathologists #pathTwitter #dermpath #dermatology #dermtwitter #dermatologia




Splendore Hoeppli phenomenon #PathTwitter #pathology #pathtwt

Cross section of the tube intraluminal gestational sac. Embryo is visible. Ectopic / tubal pregnancy at 7 weeks pregnant. #medicine #anatomy #medschool #pathology #histology #medlife #histologia #path #pathologists

Rhinosporidiosis. #medicine #anatomy #medschool #pathology #histology #medlife #histologia #path #pathologists #oncology


Reed-Sternberg cell 😍 #medicine #anatomy #medschool #pathology #histology #medlife #histologia #path #pathologists #oncology
Cervical biopsy. Squamous intraepithelial lesion. What’s the grade? Why? . . . #medicine #anatomy #medschool #pathology #histology #medlife #histologia #path #pathologists #oncology

Guess what are these beautiful cells?

Giant cell with a cute asteroid body from a FNA cell block of a lymph node tissue in a 55yo female

United States Trends
- 1. Duke N/A
- 2. #UFCVegas113 N/A
- 3. Rickea N/A
- 4. Caleb Wilson N/A
- 5. #AEWCollision N/A
- 6. Seth Trimble N/A
- 7. Almeida N/A
- 8. Jeremy Fears N/A
- 9. Boozer N/A
- 10. Jake Davis N/A
- 11. #Illini N/A
- 12. Pat Adams N/A
- 13. Michigan State N/A
- 14. James Pearce N/A
- 15. Nate Ament N/A
- 16. #GDTBATH N/A
- 17. #Svengoolie N/A
- 18. Carolina N/A
- 19. Scheyer N/A
- 20. Go Heels N/A
You might like
-
 Mahsa Chitsaz, MD
Mahsa Chitsaz, MD
@MahsaChitsaz -
 Zahra Sarrafan Chaharsoughi, MD
Zahra Sarrafan Chaharsoughi, MD
@ZSarrafan -
 Priyadharshini Sivasubramaniam
Priyadharshini Sivasubramaniam
@priyasusheil -
 Amar Bashar
Amar Bashar
@AmarBasharMD -
 Dr Sahil
Dr Sahil
@drinvincipaul -
 Mustafa A. H. El Darawany, MD
Mustafa A. H. El Darawany, MD
@Paraffinembeded -
 Med Amine, MD 🔬
Med Amine, MD 🔬
@Drmerm -
 Alaa Rowaid
Alaa Rowaid
@AlaaRowaid_88 -
 Negin Farsi
Negin Farsi
@Neginfar1 -
 Roman Brudnik
Roman Brudnik
@brudpath -
 Viviane Ribeiro
Viviane Ribeiro
@ViviianeRF -
 GiovanniMariaGrilli
GiovanniMariaGrilli
@Grilli15
Something went wrong.
Something went wrong.
















































































































































